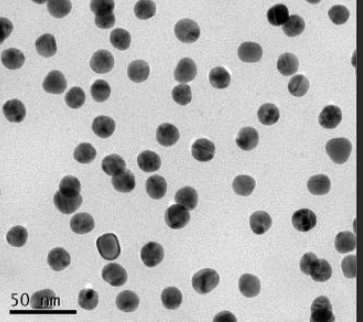
HA-OVA-AuNPs

HA-OVA-AuNPs 透明质酸-卵白蛋白-金纳米粒子 卵白蛋白修饰纳米金/纳米银
企业产商品编码称: 透明色质酸-卵白蛋白酶-金nm微粒 国外英文明称:HA-OVA-AuNPs 使用用途:科技创新情况:液体/咖啡豆/液体护肤品尺寸:1g/5g/10g手机截图:冰箱存贮经济条件:-20℃处理的时间:2年文章的话:金奈米a粒子束是科研很早的另外一种奈米的材料,在海洋生物科研中普通将其称是胶体溶液金。它的a粒子束尺码普通在1~100nm互相,随比表面积的变现产生有所不同的色泽。
Ovalbumin-PEG-glutaric acid 鸡卵白蛋白-聚乙二醇-谷氨酸
Ovalbumin-PEG-Lysines 鸡卵白蛋白-聚乙二醇-赖氨酸
Ovalbumin-PEG-threonine 鸡卵白蛋白-聚乙二醇-苏氨酸
Ovalbumin-PEG-leucine 鸡卵白蛋白-聚乙二醇-亮氨酸
Ovalbumin-PEG-valine 鸡卵白蛋白-聚乙二醇-缬氨酸
Ovalbumin-PEG-Tryptophan 鸡卵白蛋白-聚乙二醇-色氨酸
工厂:浙江pg电子娱乐游戏app 海洋生物网络有限机构机构保管时长:2年维持:冰箱舒心消息提醒:仅作科技,不允许用到人体肌肉实验报告

pg电子娱乐游戏app
微信公众号
官方微信